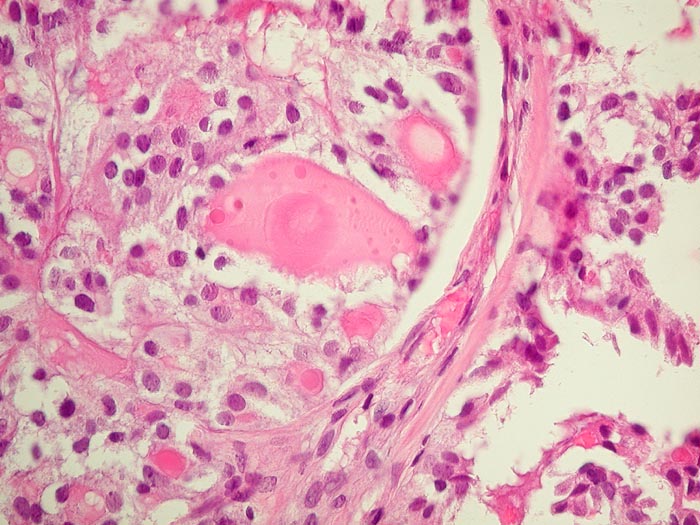

PathoPic – image database / PathoPic ID 2786 - Metastase follikuläres Schilddrüsenkarzinom
de
Diagnose
Metastase follikuläres Schilddrüsenkarzinom
Diagnose Gruppe
maligner Tumor
Topographie
Knochen, Becken
Topographie Gruppe
Knochen, Knorpel, Gelenke
Beschreibung
Die Metastase zeigt eine Morphologie vergleichbar mit normalem Schilddrüsenparenchym.
Zusatzbefund
Die Tumorzellen reagieren positiv mit Thyreoglobulin sowie mit dem nukleären Transkriptionsfaktor TTF-1
Klinik
Kein bekanntes Schilddrüsenkarzinom. Vor 30 Jahren Adenokarzinom des Kolons.
Bilder Typ
Histologie
Alter
82
Geschlecht
unbekannt
Datum
Ersteintrag: 18.03.2002